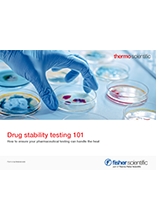
Test de stabilité des médicaments 101

Principaux avantages
Pourquoi choisir les incubateurs microbiologiques Thermo Scientific™ Heratherm™ ?
Adapté aux environnements contrôlés
Saisie des données conformément à la norme 21 CFR Part 11
Tests de stabilité selon ICH Q1A (R2) dans les chambres de stabilité
Tests de photostabilité, y compris l'exposition aux UV, conformément à la ligne directrice ICH Q1B, dans des chambres à lumière
Engagé dans le développement durable
Technologie Peltier pour une efficacité thermique intégrée
Réservoir d'eau intégré pour une humidification économe en eau
Éclairage LED pour les chambres à lumière à faible consommation d'énergie
Conçu pour une utilisation facile
Interface utilisateur intuitive à écran tactile
Hauteur ergonomique
Livré debout, prêt à être installé
Test de stabilité des médicaments
Comment s'assurer que vos essais pharmaceutiques peuvent supporter la chaleur ?

Chambres de stabilité
De l'identification des matières premières aux produits pharmaceutiques finis et conditionnés, les tests de stabilité des médicaments constituent une étape critique pour la recherche et le développement (R&D) et le contrôle de la qualité (CQ), avec un impact considérable sur la sécurité des consommateurs. Les chambres de stabilité sont des enceintes utilisées pour tester le profil de stabilité" d'un médicament, c'est-à-dire la documentation sur la manière dont la qualité d'un médicament peut varier dans le temps sous l'influence de divers paramètres. La température et l'humidité sont des facteurs clés contrôlés lors de l'utilisation des chambres de stabilité.
Un contrôle maximal du processus de test de stabilité permet aux fabricants de produits pharmaceutiques d'obtenir les résultats les plus complets et les plus précis, de la manière la plus efficace possible, en évitant tout problème susceptible d'influencer négativement l'efficacité des résultats des tests et/ou la qualité des produits fabriqués".
Découvrir le produit1 Écran tactile
Le panneau de commande à écran tactile, facile à utiliser, guide le processus de démarrage et les choix de cycles d'éclairage préprogrammés sont immédiatement disponibles.
2 Contrôle de l'humidité
Le réservoir d'eau intégré fournit de l'eau à l'humidité relative (RH) souhaitée à l'intérieur de la chambre. Le système d'humidification est conçu pour minimiser les condensats dans les applications standard, tout en augmentant l'efficacité du laboratoire.
3 Accessoires
Le chargement de l'enceinte est facile grâce aux étagères qui s'extraient et supportent un poids maximal de 25 kg. Des étagères renforcées en acier inoxydable pouvant supporter jusqu'à 70 kg sont également disponibles.
4 Manœuvrabilité
Livré debout, prêt à être déballé, branché et mis en service dès la livraison. Chaque modèle 750L passe dans les cadres de porte standard et est doté de roulettes qui se verrouillent et se déverrouillent pour faciliter le déplacement et le positionnement dans le laboratoire.

Acheter maintenant
Produits associés
Vous pourriez également être intéressé par
Documentation
Test de stabilité des médicaments 101
En savoir plus sur la façon de s'assurer que vos tests pharmaceutiques peuvent supporter la chaleur.
Télécharger le document
Brochure sur les chambres climatiques Heratherm™
Les Incubateurs microbiologiques Heratherm™ offrent un contrôle environnemental exceptionnel dans une chambre sans tracas, facile à programmer et à utiliser.
Télécharger le document
Infographie sur les chambres climatiques Heratherm™
En savoir plus sur les principales caractéristiques des Incubateurs microbiologiques Heratherm™.
Télécharger le document




